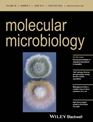
cover_small

02.07.2014

Dr. Otto Seibert Preise für Mario Gründlinger und Martin Kumnig
Das Archäologische Museum im 3. Stock des Universitätshauptgebäudes bot gestern ein angemessenes Ambiente für die Verleihung der Dr. Otto Seibert Preise an Forscher:innen beider Universitäten. Dr. Mario Gründlinger von der Sektion für Molekularbiologie erhielt den Dr. Otto Seibert Wissenschafts-Förderungspreis. Der Dr. Otto Seibert Preis für Forschung zur Förderung gesellschaftlich Benachteiligter ging an Priv.-Doz. Mag. Dr. Martin Kumnig von der Univ.-Klinik für Medizinische Psychologie.
In einem gemeinsamen Festakt der Medizinischen Universität Innsbruck und der Universität Innsbruck fand gestern die Verleihung der Otto Seibert Preise statt. Die Preisträgerinnen und Preisträger der beiden Universitäten wurden von Univ.-Prof.in Dr.in Sabine Schindler, Vizerektorin für Forschung der Universität Innsbruck und Univ.-Prof.in Dr.in Christine Bandtlow, Vizerektorin für Forschung und Internationales der Medizinischen Universität Innsbruck, begrüßt. Neben den Vertreter:innen der Universität Innsbruck erhielt der Mikrobiologe Dr. Mario Gründlinger, PhD aus der Arbeitsgruppe von ao. Univ.-Prof. Dr. Hubertus Haas von der Sektion für Molekularbiologie (Direktor Univ.-Prof. Dr. Peter Loidl) des Innsbrucker Biozentrums einen der Dr. Otto Seibert Wissenschafts-Förderungspreise, der Klinische Psychologe und Gesundheitspsychologe Priv.-Doz. Mag. Dr. Martin Kumnig von der Univ.-Klinik für Medizinische Psychologie (Direktor o. Univ.-Prof. Dr. Gerhard Schüßler) wurde mit dem Dr. Otto Seibert Preis für Forschung zur Förderung gesellschaftlich Benachteiligter ausgezeichnet.
Molekulare Einblicke in das Siderophorsystem
Das zentrale Forschungsinteresse von Mario Gründlinger fokussiert auf die Verbesserung von Diagnose und Therapie von Pilzinfektionen. Bei immunsupprimierten Patient:innen führt eine invasive Infektion mit dem opportunistisch pathogenen Schimmelpilz Aspergillus fumigatus zu schwerwiegenden und oftmals lebensbedrohlichen Komplikationen. Die Arbeitsgruppe um ao.Univ.-Prof. Hubertus Haas konnte schon in früheren Arbeiten zeigen, dass die Eisenaufnahme über Siderophore (niedermolekulare Chelatoren, die vom Pilz in die Umgebung sezerniert werden und nach Beladung mit Eisen wieder aufgenommen werden) eine zentrale Rolle in der Virulenz von Aspergillus fumigatus spielt und daher ein attraktives Ziel für die Verbesserung von Diagnose und Therapie von Pilzinfektionen darstellt. Dazu ist aber eine detaillierte Kenntnis des Pilz-spezifischen Siderophorsystems auf molekularer Ebene notwendig. Preisträger Gründlinger konnte in seiner Dissertation zeigen, dass drei der an der Siderophorbiosynthese beteiligten Enzyme in Peroxisomen lokalisiert sind. „Peroxisomen sind Organellen mit einer einfachen Membran und einem Durchmesser von 0,1-1 µm, die vielfältige metabolische Funktionen der eukaryotischen Zelle übernehmen – die Rolle in der Siderophorbiosynthese ist gänzlich neu. Verschiedene, durch genetische Manipulation verursachte Blockaden der peroxisomalen Lokalisierung dieser Enzyme führten zu einem Defekt in der Siderophorbiosynthese und in der Folge zu verringertem Wachstum und Sporulation“, erklärt Mario Gründlinger, der außerdem zeigen konnte, dass die partielle peroxisomale Lokalisierung der Siderophorbiosynthese in den meisten Pilzen evolutionär konserviert ist, also auch in Pflanzenpathogenen und in der Biotechnologie genutzten Pilzen. Der nun mit dem Otto Seibert Wissenschaftspreis ausgezeichneten und vom FWF geförderten Arbeit widmete das Fachjournal Molecular Microbiology sogar das Titelblatt.
Zur Person
Der 34jährige Mario Gründlinger studierte Mikrobiologie in Innsbruck und absolvierte 2011 das Doktoratsstudium (PhD) an der Medizinischen Universität Innsbruck. Seit 2006 forscht der gebürtige Vorarlberger an der Sektion für Molekularbiologie des Biozentrums der Medizinischen Universität Innsbruck in der Arbeitsgruppe von ao. Univ.-Prof. Hubertus Haas. Schwerpunkt der molekularbiologischen Grundlagenforschung des Jungforschers, der 2012 bereits mit dem Österreichischen Mikrobiologie Preis der Österreichischen Gesellschaft für Hygiene, Mikrobiologie und Präventivmedizin (ÖGHMP) ausgezeichnet wurde, ist die Charakterisierung des Siderophore-Systems des opportunistisch pathogenen Pilzes Aspergillus fumigatus.
Standardisierte psychosoziale Beurteilung von Handtransplantationspatient:innen
Patient:innen, die den Verlust einer Hand oder einer oberen Extremität erlitten haben, müssen eine Vielzahl von Herausforderungen im Alltag bewältigen. Für eine ausgewählte Gruppe von Patient:innen kann die rekonstruktive Handtransplantation eine sinnvolle Option zur Wiederherstellung der natürlichen Funktionalität sowie zum Wiedergewinn von Autonomie und Lebensqualität sein. Die Forschungsprojekte von Priv.-Doz. Mag. Dr. Martin Kumnig ermöglichten die Entwicklung standardisierter Protokolle für die psychosoziale Eignungsbeurteilung und Verlaufskontrolle von Transplantationspatient:innen und wurden nun mit dem Dr. Otto Seibert Preis zur Förderung von Forschung für gesellschaftlich Benachteiligte prämiert. „Mittels dieser Protokolle können prädikative Aspekte hinsichtlich des weiteren Transplantationsverlaufs, z.B. psychosoziale Risikoprofile, bestmöglich erfasst, aber auch potentiell behandlungsbedürftige Patient:innen schnellstmöglich identifiziert und gezielt behandelt werden, wodurch die psychische Morbidität minimiert werden kann“, weiß der Klinische Psychologe und Gesundheitspsychologe, unter dessen wissenschaftlicher Leitung im März dieses Jahres der erste internationale ‚Chauvet Workshop: Standardization and Optimization of Psychosocial Outcomes in Reconstrutive Hand Transplantation‘ in Paris stattfand, an dem Fachvertreter:innen von insgesamt 15 Transplantationszentren teilnahmen und erstmals ein standardisiertes multizentrisches psychosoziales Evaluationsprotokoll erarbeitet wurde.
Zur Person
Priv.-Doz. Mag. Dr. Martin Kumnig studierte in Klagenfurt und Innsbruck Psychologie und promovierte an der Alpen-Adria-Universität Klagenfurt in Klinischer Psychologie. Es folgte die Habilitation im Fach Experimentelle Klinische Psychologie an der Medizinischen Universität Innsbruck mit der Habilitationsschrift ‚Development of Standardized Psychological Assessment Procedures and their Application in Different Diseases‘. Seit seinem Research Fellowship am William J. von Liebig Transplant Center der Mayo Clinic Rochester ist er als Senior Scientist an der Univ.-Klinik für Medizinische Psychologie tätig, ist Mitglied der ‚Reconstructive Transplantation Innsbruck (RTi)‘ und leitet zwei facheinschlägige internationale Arbeitsgruppen.
Die Preisträger:innen der Universität Innsbruck
Dr. Otto Seibert Wissenschafts-Förderungspreis:
Mag. Markus Seidl für die Publikation: From parallel to single crystallization kinetics in high-density amorphous ice, Phys. Rev. B88, 174105-1-6 (2013)
Dr. Andreas Mauracher für die Publikation: On the properties of charged and neutral, atomic and molecular helium species in helium nanodroplets: interpreting recent experiments. Mol. Phys. 112 (5-6) (2014), 794-804
Dr. Otto Seibert-Preis zur Förderung von Forschung für gesellschaftlich Benachteiligte 2014:
Ass.-Prof. Dr. Gregor Christandl, LL.M. für die Publikation: Der Schutz pflegebedürftiger Erblasser vor Fremdbestimmung – eine kritische Bestandsaufnahme. Juristische Blätter 135, 681-697 (2013)
Dr. Otto Seibert-Preis zur Förderung wissenschaftlicher Publikationen:
Dipl.-Math. Lukas Benedikt Kraus, BA für die Publikation: Der Begriff des Kontinuums bei Bernard Bolzano, Beiträge zur Bolzano-Forschung, Band 25
Mag. Jasmin Steiner für die Dissertation: „Iñaki, du musch ummi laufen!“ –Empirische Analyse von Mehrsprachigkeit und Kommunikationsstrategien in einer Fußballmannschaft
Mag. Mag. Dr. Mathias Walch für die Dissertation: Die subsidiäre Anwendbarkeit des allgemeinen Zivilrechts im GmbHG
Dr. Otto Seibert Preise
Der aus Deutschland stammende Dr. Otto Seibert war Arzt und wurde 1902 geboren. Bei einer Bergwanderung in Südtirol überanstrengte sich der Mediziner offenbar etwas. Der damalige Vizebürgermeister der Gemeinde Klobenstein, Dr. Hans Gamper, der zufällig in der Nähe war, brachte Seibert daraufhin in das nächstgelegene Krankenhaus. Seinem Helfer zutiefst dankbar gebar Dr. Seibert die Idee, eine Stiftung für Südtiroler Studierende anzulegen. Seibert nahm Kontakt mit dem damaligen Rektor der Universität Innsbruck, Prof. Rainer Sprung, auf und erzählte ihm von seinem Vorhaben. Gemeinsam arbeiteten sie einen „Stiftbrief“ aus. Otto Seibert verstarb im Jahr 1988. Der Arzt stiftete den Wissenschaftsförderungspreis, den Preis für Forschung zur Förderung gesellschaftlich Benachteiligter, den Preis zur Förderung wissenschaftlicher Publikationen sowie Stipendien für Südtiroler Studierende. Der Dr. Otto Seibert Wissenschaftspreis geht nach dem Willen des Stifters jedes Jahr an Forschende aus den Fachbereichen Rechtswissenschaften und Naturwissenschaften.
(D.Heidegger)
Links:
Fungal siderophore biosynthesis is partially localized in peroxisomes. Gründlinger M, Yasmin S, Lechner BE, Geley S, Schrettl M, Hynes M, Haas H., Mol Microbiol. 2013 Jun;88(5):862-75. Epub 2013 Apr 26.
http://dx.doi.org/10.1111/mmi.12225
Sektion für Molekukarbiologie
http://mol-biol.i-med.ac.at/
Psychological aspects of hand transplantation. Kumnig M, Jowsey SG, DiMartini A. Curr Opin Organ Transplant. 2014 April; 19(2): 188-195.
http://dx.doi.org/10.1097/MOT.0000000000000047
An overview of psychosocial assessment procedures in reconstructive hand transplantation. Kumnig M, Jowsey SG, Moreno E, Brandacher G, Azari K, Rumpold G. Transpl Int. 2014 May;27(5):417-27. Epub 2013 Nov 14.
http://dx.doi.org/10.1111/tri.12220
Case series on defense mechanisms in patients for reconstrutice hand transplantation: Consideration on transplant defense concept. Kumnig M, Jowsey SG, Moreno E, Brandacher G, Azari K, Rumpold G, RTi Work Group. Ann Transplant. 2014 May;19:233-240.
http://dx.doi.org/10.12659/aot.890326
Univ.-Klinik für Medizinische Psychologie
https://www.i-med.ac.at/patienten/ukl_medizinische_psychologie.html